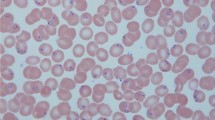

Key Points
-
Over the past decade, several key advances in imaging technologies have led to important discoveries about the biology of Plasmodium spp. parasites and their interaction with their mammalian host and mosquito vector.
-
Various electron microscopy methods, such as cryoelectron tomography and cryo-X-ray tomography, together with the introduction of super-resolution fluorescence microscopy has greatly expanded our knowledge of the architecture and structure of various life cycle stages of Plasmodium spp. parasites. In particular, these techniques have helped to elucidate the molecular mechanisms of merozoite attachment and invasion, and the structural basis for sporozoite motility. Likewise, these imaging tools have been key to the study of erythrocyte remodelling at previously unachieved resolutions.
-
High-speed imaging has shed light on sporozoite motility within the mammalian host, on egress of Plasmodium spp. blood stages from the infected erythrocyte, and on the mechanisms of defence used by liver-stage parasites to avoid the cytosolic immune response in hepatocytes.
-
Intravital microscopy (IVM) has served as a powerful technique to dissect sporozoite deposition in the skin and the subsequent journey of the parasite to hepatocytes. Likewise, this technique led to the discovery of merosomes — a stage of pre-erythrocytic parasites that was previously not known to exist. In addition to the skin and liver stages, IVM has been applied to view organs, including the placenta, the lungs and the brain, in animal models infected with Plasmodium spp.
-
Long-term time-lapse microscopy has enabled the first visualization of the complete Plasmodium falciparum erythrocytic life cycle and of all the Plasmodium berghei pre-erythrocytic developmental stages in vitro. This imaging has revealed a range of dynamic host–pathogen interactions that were previously unknown.
-
The development of new imaging techniques and the further application of existing methods in malaria research will continue to expand our knowledge of Plasmodium spp. parasites in the future and will help to answer several fundamental biological questions related to parasite ultrastructure, parasite-induced signalling in the host cell and parasite transmission.
Abstract
Over the past decade, major advances in imaging techniques have enhanced our understanding of Plasmodium spp. parasites and their interplay with mammalian hosts and mosquito vectors. Cryoelectron tomography, cryo-X-ray tomography and super-resolution microscopy have shifted paradigms of sporozoite and gametocyte structure, the process of erythrocyte invasion by merozoites, and the architecture of Maurer's clefts. Intravital time-lapse imaging has been revolutionary for our understanding of pre-erythrocytic stages of rodent Plasmodium parasites. Furthermore, high-speed imaging has revealed the link between sporozoite structure and motility, and improvements in time-lapse microscopy have enabled imaging of the entire Plasmodium falciparum erythrocytic cycle and the complete Plasmodium berghei pre-erythrocytic stages for the first time. In this Review, we discuss the contribution of key imaging tools to these and other discoveries in the malaria field over the past 10 years.
This is a preview of subscription content, access via your institution
Access options
Subscribe to this journal
Receive 12 print issues and online access
$259.00 per year
only $21.58 per issue
Buy this article
- Purchase on SpringerLink
- Instant access to the full article PDF.
USD 39.95
Prices may be subject to local taxes which are calculated during checkout




Similar content being viewed by others
References
World Health Organization. World Malaria Report (WHO, 2015).
Cyrklaff, M. et al. Cryoelectron tomography reveals periodic material at the inner side of subpellicular microtubules in apicomplexan parasites. J. Exp. Med. 204, 1281–1287 (2007).
Kudryashev, M. et al. Structural basis for chirality and directional motility of Plasmodium sporozoites. Cell. Microbiol. 14, 1757–1768 (2012).
Cyrklaff, M. et al. Hemoglobins S and C interfere with actin remodeling in Plasmodium falciparum-infected erythrocytes. Science 334, 1283–1286 (2011).
Kaiser, G. et al. High resolution microscopy reveals an unusual architecture of the Plasmodium berghei endoplasmic reticulum. Mol. Microbiol. http://dx.doi.org/10.1111/mmi.13490 (2016).
Gilson, P. R. & Crabb, B. S. Morphology and kinetics of the three distinct phases of red blood cell invasion by Plasmodium falciparum merozoites. Int. J. Parasitol. 39, 91–96 (2009).
Riglar, D. T. et al. Super-resolution dissection of coordinated events during malaria parasite invasion of the human erythrocyte. Cell Host Microbe 9, 9–20 (2011). This study uses 3D SIM imaging to visualize the invasion of human erythrocytes by P. falciparum merozoites, and identifies key steps in invasion, including specific tight junction formation and commitment to invasion.
Amino, R. et al. Quantitative imaging of Plasmodium transmission from mosquito to mammal. Nat. Med. 12, 220–224 (2006). This paper reports two previously unknown phenomena: that only a portion of the parasites that are deposited in the skin enter blood capillaries, and that many parasites are drained into the lymphatics, where they are mostly destroyed.
Tavares, J. et al. Role of host cell traversal by the malaria sporozoite during liver infection. J. Exp. Med. 210, 905–915 (2013). This investigation is the first to show that sporozoites can enter the liver hepatocytes through several pathways, including cell traversal-dependent and cell traversal-independent mechanisms.
Münter, S. et al. Plasmodium sporozoite motility is modulated by the turnover of discrete adhesion sites. Cell Host Microbe 6, 551–562 (2009).
Gruring, C. et al. Development and host cell modifications of Plasmodium falciparum blood stages in four dimensions. Nat. Commun. 2, 165 (2011). This work uses time-lapse imaging to identify host cell modifications throughout the complete P. falciparum life cycle in vitro.
Prado, M. et al. Long-term live imaging reveals cytosolic immune responses of host hepatocytes against Plasmodium infection and parasite escape mechanisms. Autophagy 11, 1561–1579 (2015).
Vanderberg, J. P., Rhodin, J. & Yoeli, M. Electron microscopic and histochemical studies of sporozoite formation in Plasmodium berghei. J. Protozool. 14, 82–103 (1967).
Russell, D. G. & Sinden, R. E. Three-dimensional study of the intact cytoskeleton of coccidian sporozoites. Int. J. Parasitol. 12, 221–226 (1982).
Dubremetz, J. F., Garcia-Réguet, N., Conseil, V. & Fourmaux, M. N. Apical organelles and host-cell invasion by Apicomplexa. Int. J. Parasitol. 28, 1007–1013 (1998).
Kudryashev, M., Lepper, S., Baumeister, W., Cyrklaff, M. & Frischknecht, F. Geometric constrains for detecting short actin filaments by cryogenic electron tomography. PMC Biophys. 3, 6 (2010).
Khater, E. I., Sinden, R. E. & Dessens, J. T. A malaria membrane skeletal protein is essential for normal morphogenesis, motility, and infectivity of sporozoites. J. Cell Biol. 167, 425–432 (2004).
Battista, A., Frischknecht, F. & Schwarz, U. S. Geometrical model for malaria parasite migration in structured environments. Phys. Rev. E Stat. Nonlin. Soft Matter Phys. 90, 042720 (2014).
Hopp, C. S. et al. Longitudinal analysis of Plasmodium sporozoite motility in the dermis reveals component of blood vessel recognition. eLife 4, e07789 (2015).
Vanderberg, J. P. & Frevert, U. Intravital microscopy demonstrating antibody-mediated immobilisation of Plasmodium berghei sporozoites injected into skin by mosquitoes. Int. J. Parasitol. 34, 991–996 (2004).
Montagna, G. N. et al. Critical role for heat shock protein 20 (HSP20) in migration of malarial sporozoites. J. Biol. Chem. 287, 2410–2422 (2012).
Hellmann, J. K. et al. Environmental constraints guide migration of malaria parasites during transmission. PLoS Pathog. 7, e1002080 (2011).
Formaglio, P., Tavares, J., Menard, R. & Amino, R. Loss of host cell plasma membrane integrity following cell traversal by Plasmodium sporozoites in the skin. Parasitol. Int. 63, 237–244 (2014).
Amino, R. et al. Host cell traversal is important for progression of the malaria parasite through the dermis to the liver. Cell Host Microbe 3, 88–96 (2008).
Menard, R. et al. Looking under the skin: the first steps in malarial infection and immunity. Nat. Rev. Microbiol. 11, 701–712 (2013).
Sinnis, P. & Coppi, A. A. Long and winding road: the Plasmodium sporozoite's journey in the mammalian host. Parasitol. Int. 56, 171–178 (2007).
Gueirard, P. et al. Development of the malaria parasite in the skin of the mammalian host. Proc. Natl Acad. Sci. USA 107, 18640–18645 (2010).
Douglas, R. G., Amino, R., Sinnis, P. & Frischknecht, F. Active migration and passive transport of malaria parasites. Trends Parasitol. 31, 357–362 (2015).
Panchal, D. & Bhanot, P. Activity of a trisubstituted pyrrole in inhibiting sporozoite invasion and blocking malaria infection. Antimicrob. Agents Chemother. 54, 4269–4274 (2010).
Hellmann, J. K., Münter, S., Wink, M. & Frischknecht, F. Synergistic and additive effects of epigallocatechin gallate and digitonin on Plasmodium sporozoite survival and motility. PLoS ONE 5, e8682 (2010).
Hegge, S. et al. Multistep adhesion of Plasmodium sporozoites. FASEB J. 24, 2222–2234 (2010).
Perschman, N., Hellmann, J. K., Frischknecht, F. & Spatz, J. P. Induction of malaria parasite migration by synthetically tunable microenvironments. Nano Lett. 11, 4468–4474 (2011).
Sultan, A. A. et al. TRAP is necessary for gliding motility and infectivity of Plasmodium sporozoites. Cell 90, 511–522 (1997).
Carey, A. F. et al. Calcium dynamics of Plasmodium berghei sporozoite motility. Cell. Microbiol. 16, 768–783 (2014).
Bane, K. S. et al. The actin filament-binding protein coronin regulates motility in Plasmodium sporozoites. PLoS Pathog. 12, e1005710 (2016).
Soldati, D., Foth, B. J. & Cowman, A. F. Molecular and functional aspects of parasite invasion. Trends Parasitol. 20, 567–574 (2004).
Hegge, S. et al. Direct manipulation of malaria parasites with optical tweezers reveals distinct functions of Plasmodium surface proteins. ACS Nano 6, 4648–4662 (2012).
Quadt, K. A., Streichfuss, M., Moreau, C. A., Spatz, J. P. & Frischknecht, F. Coupling of retrograde flow to force production during malaria parasite migration. ACS Nano 10, 2091–2102 (2016).
Hochstetter, A. & Pfohl, T. Motility, force generation, and energy consumption of unicellular parasites. Trends Parasitol. 32, 531–541 (2016).
Voza, T., Miller, J. L., Kappe, S. H. & Sinnis, P. Extrahepatic exoerythrocytic forms of rodent malaria parasites at the site of inoculation: Clearance after immunization, susceptibility to primaquine, and contribution to blood-stage infection. Infect. Immun. 80, 2158–2164 (2012).
Frevert, U., Späth, G. F. & Yee, H. Exoerythrocytic development of Plasmodium gallinaceum in the white leghorn chicken. Int. J. Parasitol. 38, 655–672 (2008).
Chakravarty, S. et al. CD8+ T lymphocytes protective against malaria liver stages are primed in skin-draining lymph nodes. Nat. Med. 13, 1035–1041 (2007).
Coppi, A. et al. The malaria circumsporozoite protein has two functional domains, each with distinct roles as sporozoites journey from mosquito to mammalian host. J. Exp. Med. 208, 341–356 (2011).
Prudencio, M., Rodriguez, A. & Mota, M. M. The silent path to thousands of merozoites: the Plasmodium liver stage. Nat. Rev. Microbiol. 4, 849–856 (2006).
Sturm, A. et al. Manipulation of host hepatocytes by the malaria parasite for delivery into liver sinusoids. Science 313, 1287–1290 (2006). This study includes both in vivo and in vitro experiments that unravel the last unknown stage in the life cycle of Plasmodium spp. parasites: the transport of hepatocyte-derived merozoites into liver sinusoids within parasite-filled host cell vesicles called merosomes.
Frevert, U. et al. Intravital observation of Plasmodium berghei sporozoite infection of the liver. PLoS Biol. 3, e192 (2005).
Baer, K. et al. Kupffer cells are obligatory for Plasmodium yoelii sporozoite infection of the liver. Cell. Microbiol. 9, 397–412 (2007).
Pradel, G. & Frevert, U. Malaria sporozoites actively enter and pass through rat Kupffer cells prior to hepatocyte invasion. Hepatology 33, 1154–1165 (2001).
Ishino, T., Chinzei, Y. & Yuda, M. A Plasmodium sporozoite protein with a membrane attack complex domain is required for breaching the liver sinusoidal cell layer prior to hepatocyte infection. Cell. Microbiol. 7, 199–208 (2005).
Vestweber, D. How leukocytes cross the vascular endothelium. Nat. Rev. Immunol. 15, 692–704 (2015).
Bano, N., Romano, J. D., Jayabalasingham, B. & Coppens, I. Cellular interactions of Plasmodium liver stage with its host mammalian cell. Int. J. Parasitol. 37, 1329–1341 (2007).
Grützke, J. et al. The spatiotemporal dynamics and membranous features of the Plasmodium liver stage tubovesicular network. Traffic 15, 362–382 (2014).
Sturm, A. et al. Alteration of the parasite plasma membrane and the parasitophorous vacuole membrane during exo-erythrocytic development of malaria parasites. Protist 160, 51–63 (2009).
Ingmundson, A., Nahar, C., Brinkmann, V., Lehmann, M. J. & Matuschewski, K. The exported Plasmodium berghei protein IBIS1 delineates membranous structures in infected red blood cells. Mol. Microbiol. 83, 1229–1243 (2012).
Mueller, A.-K. et al. Plasmodium liver stage developmental arrest by depletion of a protein at the parasite–host interface. Proc. Natl Acad. Sci. USA 102, 3022–3027 (2005).
Mueller, A.-K., Labaied, M., Kappe, S. H. I. & Matuschewski, K. Genetically modified Plasmodium parasites as a protective experimental malaria vaccine. Nature 433, 164–167 (2005).
Orito, Y. et al. Liver-specific protein 2: a Plasmodium protein exported to the hepatocyte cytoplasm and required for merozoite formation. Mol. Microbiol. 87, 66–79 (2013).
Thieleke-Matos, C. et al. Host cell autophagy contributes to Plasmodium liver development. Cell. Microbiol. 18, 437–450 (2016).
Gomes-Santos, C. S. S. et al. Highly dynamic host actin reorganization around developing Plasmodium inside hepatocytes. PLoS ONE 7, e29408 (2012).
Graewe, S. et al. Hostile takeover by Plasmodium: reorganization of parasite and host cell membranes during liver stage egress. PLoS Pathog. 7, e1002224 (2011).
Vaughan, A. M. et al. Complete Plasmodium falciparum liver-stage development in liver-chimeric mice. J. Clin. Invest. 122, 3618–3628 (2012).
Spillman, N. J., Beck, J. R. & Goldberg, D. E. Protein export into malaria parasite-infected erythrocytes: mechanisms and functional consequences. Annu. Rev. Biochem. 84, 813–841 (2015).
Mundwiler-Pachlatko, E. & Beck, H.-P. Maurer's clefts, the enigma of Plasmodium falciparum. Proc. Natl Acad. Sci. USA 110, 19987–19994 (2013).
Wissing, F., Sanchez, C. P., Rohrbach, P., Ricken, S. & Lanzer, M. Illumination of the malaria parasite Plasmodium falciparum alters intracellular pH. Implications for live cell imaging. J. Biol. Chem. 277, 37747–37755 (2002).
Haase, S. & de Koning-Ward, T. F. New insights into protein export in malaria parasites. Cell. Microbiol. 12, 580–587 (2010).
Maier, A. G., Cooke, B. M., Cowman, A. F. & Tilley, L. Malaria parasite proteins that remodel the host erythrocyte. Nat. Rev. Microbiol. 7, 341–354 (2009).
Spielmann, T. et al. A cluster of ring stage-specific genes linked to a locus implicated in cytoadherence in Plasmodium falciparum codes for PEXEL-negative and PEXEL-positive proteins exported into the host cell. Mol. Biol. Cell 17, 3613–3624 (2006).
Spycher, C. et al. Genesis of and trafficking to the Maurer's clefts of Plasmodium falciparum-infected erythrocytes. Mol. Cell. Biol. 26, 4074–4085 (2006).
Tilley, L., Sougrat, R., Lithgow, T. & Hanssen, E. The twists and turns of Maurer's cleft trafficking in P. falciparum-infected erythrocytes. Traffic 9, 187–197 (2008).
de Koning-Ward, T. F., Dixon, M. W. A., Tilley, L. & Gilson, P. R. Plasmodium species: master renovators of their host cells. Nat. Rev. Microbiol. 14, 494–507 (2016).
Papakrivos, J., Newbold, C. I. & Lingelbach, K. A potential novel mechanism for the insertion of a membrane protein revealed by a biochemical analysis of the Plasmodium falciparum cytoadherence molecule PfEMP-1. Mol. Microbiol. 55, 1272–1284 (2005).
Taraschi, T. F., Trelka, D., Martinez, S., Schneider, T. & O'Donnell, M. E. Vesicle-mediated trafficking of parasite proteins to the host cell cytosol and erythrocyte surface membrane in Plasmodium falciparum infected erythrocytes. Int. J. Parasitol. 31, 1381–1391 (2001).
Hanssen, E. et al. Electron tomography of the Maurer's cleft organelles of Plasmodium falciparum-infected erythrocytes reveals novel structural features. Mol. Microbiol. 67, 703–718 (2008). Together with reference 4, this study uses sophisticated cryoelectron and electron tomography experiments to show that Maurer's clefts are connected to the RBC membrane by stalk-like tethers and/or host-derived actin cytoskeleton, which the parasite induces and to which transport vesicles are attached.
Hanssen, E. et al. Cryo transmission X-ray imaging of the malaria parasite, P. falciparum. J. Struct. Biol. 173, 161–168 (2011).
Hanssen, E. et al. Whole cell imaging reveals novel modular features of the exomembrane system of the malaria parasite, Plasmodium falciparum. Int. J. Parasitol. 40, 123–134 (2010).
Pachlatko, E. et al. MAHRP2, an exported protein of Plasmodium falciparum, is an essential component of Maurer's cleft tethers. Mol. Microbiol. 77, 1136–1152 (2010).
Rug, M. et al. Export of virulence proteins by malaria-infected erythrocytes involves remodeling of host actin cytoskeleton. Blood 124, 3459–3468 (2014).
Bannister, L. H. & Mitchell, G. H. The malaria merozoite, forty years on. Parasitology 136, 1435–1444 (2009).
Gilberger, T.-W., Thompson, J. K., Reed, M. B., Good, R. T. & Cowman, A. F. The cytoplasmic domain of the Plasmodium falciparum ligand EBA-175 is essential for invasion but not protein trafficking. J. Cell Biol. 162, 317–327 (2003).
Rayner, J. C., Vargas-Serrato, E., Huber, C. S., Galinski, M. R. & Barnwell, J. W. A Plasmodium falciparum homologue of Plasmodium vivax reticulocyte binding protein (PvRBP1) defines a trypsin-resistant erythrocyte invasion pathway. J. Exp. Med. 194, 1571–1582 (2001).
Singh, K. et al. Subdomain 3 of Plasmodium falciparum VAR2CSA DBL3x is identified as a minimal chondroitin sulfate A-binding region. J. Biol. Chem. 285, 24855–24862 (2010).
Srinivasan, P. et al. Binding of Plasmodium merozoite proteins RON2 and AMA1 triggers commitment to invasion. Proc. Natl Acad. Sci. USA 108, 13275–13280 (2011).
Weiner, A. et al. 3D nuclear architecture reveals coupled cell cycle dynamics of chromatin and nuclear pores in the malaria parasite Plasmodium falciparum. Cell. Microbiol. 13, 967–977 (2011).
Keeley, A. & Soldati, D. The glideosome: a molecular machine powering motility and host-cell invasion by Apicomplexa. Trends Cell Biol. 14, 528–532 (2004).
Besteiro, S., Dubremetz, J.-F. & Lebrun, M. The moving junction of apicomplexan parasites: a key structure for invasion. Cell. Microbiol. 13, 797–805 (2011).
Lamarque, M. et al. The RON2–AMA1 interaction is a critical step in moving junction-dependent invasion by apicomplexan parasites. PLoS Pathog. 7, e1001276 (2011).
Richard, D. et al. Interaction between Plasmodium falciparum apical membrane antigen 1 and the rhoptry neck protein complex defines a key step in the erythrocyte invasion process of malaria parasites. J. Biol. Chem. 285, 14815–14822 (2010).
Giovannini, D. et al. Independent roles of apical membrane antigen 1 and rhoptry neck proteins during host cell invasion by Apicomplexa. Cell Host Microbe 10, 591–602 (2011).
Lamarque, M. H. et al. Plasticity and redundancy among AMA–RON pairs ensure host cell entry of Toxoplasma parasites. Nat. Commun. 5, 4098 (2014).
Yap, A. et al. Conditional expression of apical membrane antigen 1 in Plasmodium falciparum shows it is required for erythrocyte invasion by merozoites. Cell. Microbiol. 16, 642–656 (2014).
Bargieri, D. Y. et al. Apical membrane antigen 1 mediates apicomplexan parasite attachment but is dispensable for host cell invasion. Nat. Commun. 4, 2552 (2013).
Li, D. et al. Extended-resolution structured illumination imaging of endocytic and cytoskeletal dynamics. Science 349, aab3500 (2015).
Crick, A. J. et al. Quantitation of malaria parasite–erythrocyte cell–cell interactions using optical tweezers. Biophys. J. 107, 846–853 (2014).
Dasgupta, S. et al. Membrane-wrapping contributions to malaria parasite invasion of the human erythrocyte. Biophys. J. 107, 43–54 (2014).
Abkarian, M., Massiera, G., Berry, L., Roques, M. & Braun-Breton, C. A novel mechanism for egress of malarial parasites from red blood cells. Blood 117, 4118–4124 (2011).
Koussis, K. et al. A multifunctional serine protease primes the malaria parasite for red blood cell invasion. EMBO J. 28, 725–735 (2009).
Joice, R. et al. Plasmodium falciparum transmission stages accumulate in the human bone marrow. Sci. Transl. Med. 6, 244re5 (2014).
Dearnley, M. K. et al. Origin, composition, organization and function of the inner membrane complex of Plasmodium falciparum gametocytes. J. Cell Sci. 125, 2053–2063 (2012).
Dearnley, M. et al. Reversible host cell remodeling underpins deformability changes in malaria parasite sexual blood stages. Proc. Natl Acad. Sci. USA 113, 4800–4805 (2016).
Aingaran, M. et al. Host cell deformability is linked to transmission in the human malaria parasite Plasmodium falciparum. Cell. Microbiol. 14, 983–993 (2012). This research quantitatively assesses the changes in gametocyte deformability at different stages of maturation, using in vitro capillary assays and 3D finite-element whole-cell modelling.
Chotivanich, K. et al. Central role of the spleen in malaria parasite clearance. J. Infect. Dis. 185, 1538–1541 (2002).
del Portillo, H. A. et al. The role of the spleen in malaria. Cell. Microbiol. 14, 343–355 (2012).
Engwerda, C. R., Beattie, L. & Amante, F. H. The importance of the spleen in malaria. Trends Parasitol. 21, 75–80 (2005).
Buffet, P. A. et al. The pathogenesis of Plasmodium falciparum malaria in humans: insights from splenic physiology. Blood 117, 381–392 (2011).
Hanssen, E. et al. Soft X-ray microscopy analysis of cell volume and hemoglobin content in erythrocytes infected with asexual and sexual stages of Plasmodium falciparum. J. Struct. Biol. 177, 224–232 (2012).
Kono, M. et al. Evolution and architecture of the inner membrane complex in asexual and sexual stages of the malaria parasite. Mol. Biol. Evol. 29, 2113–2132 (2012).
Hliscs, M. et al. Organization and function of an actin cytoskeleton in Plasmodium falciparum gametocytes. Cell. Microbiol. 17, 207–225 (2015).
Schröder, R. R. Advances in electron microscopy: a qualitative view of instrumentation development for macromolecular imaging and tomography. Arch. Biochem. Biophys. 581, 25–38 (2015).
Mahamid, J. et al. Visualizing the molecular sociology at the HeLa cell nuclear periphery. Science. 351, 969–972 (2016).
Zhang, P. Correlative cryo-electron tomography and optical microscopy of cells. Curr. Opin. Struct. Biol. 23, 763–770 (2013).
Pampaloni, F., Ansari, N. & Stelzer, E. H. High-resolution deep imaging of live cellular spheroids with light-sheet-based fluorescence microscopy. Cell Tissue Res. 352, 161–177 (2013).
Lemon, W. C. et al. Whole-central nervous system functional imaging in larval Drosophila. Nat. Commun. 6, 7924 (2015).
Tomer, R., Khairy, K., Amat, F. & Keller, P. J. Quantitative high-speed imaging of entire developing embryos with simultaneous multiview light-sheet microscopy. Nat. Methods 9, 755–763 (2012).
Wilson, L. G., Carter, L. M. & Reece, S. E. High-speed holographic microscopy of malaria parasites reveals ambidextrous flagellar waveforms. Proc. Natl Acad. Sci. USA 110, 18769–18774 (2013). This report explores a novel imaging technique (high-speed holographic microscopy) to reveal the relevance of chirality in the structure of the axoneme and microtubules in male gametes: their chirality is linked with the beating motion of the gamete.
Martin, K. et al. Spatio-temporal co-ordination of RhoA, Rac1 and Cdc42 activation during prototypical edge protrusion and retraction dynamics. Sci. Rep. 6, 21901 (2016).
Cohen, A. E. Optogenetics: turning the microscope on its head. Biophys. J. 110, 997–1003 (2016).
Chen, B.-C. et al. Lattice light sheet microscopy: imaging molecules to embryos at high spatiotemporal resolution. Science 346, 1257998 (2014).
Nikic´, I. et al. Minimal tags for rapid dual-color live-cell labeling and super-resolution microscopy. Angew. Chem. Int. Ed. Engl. 53, 2245–2249 (2014).
Lemke, E. A. & Schultz, C. Principles for designing fluorescent sensors and reporters. Nat. Chem. Biol. 7, 480–483 (2011).
Li, A. et al. Molecular mechanistic insights into the endothelial receptor mediated cytoadherence of Plasmodium falciparum-infected erythrocytes. PLoS ONE 6, e16929 (2011).
Li, A., Mansoor, A. H., Tan, K. S. W. & Lim, C. T. Observations on the internal and surface morphology of malaria infected blood cells using optical and atomic force microscopy. J. Microbiol. Methods 66, 434–439 (2006).
Quadt, K. A. et al. The density of knobs on Plasmodium falciparum-infected erythrocytes depends on developmental age and varies among isolates. PLoS ONE 7, e45658 (2012).
Aikawa, M. et al. Membrane knobs of unfixed Plasmodium falciparum-infected erythrocytes: new findings as revealed by atomic force microscopy and surface potential spectroscopy. Exp. Parasitol. 84, 339–343 (1996).
Carvalho, P. A., Diez–Silva, M., Chen, H., Dao, M. & Suresh, S. Cytoadherence of erythrocytes invaded by Plasmodium falciparum: quantitative contact-probing of a human malaria receptor. Acta Biomater. 9, 6349–6359 (2013).
Xu, X. et al. Probing the cytoadherence of malaria infected red blood cells under flow. PLoS ONE 8, e64763 (2013).
Ando, T., Uchihashi, T. & Kodera, N. High-speed AFM and applications to biomolecular systems. Annu. Rev. Biophys. 42, 393–414 (2013).
Shibata, M., Uchihashi, T., Ando, T. & Yasuda, R. Long-tip high-speed atomic force microscopy for nanometer-scale imaging in live cells. Sci. Rep. 5, 8724 (2015).
Müller, D. J. & Dufrêne, Y. F. Atomic force microscopy as a multifunctional molecular toolbox in nanobiotechnology. Nat. Nanotechnol. 3, 261–269 (2008).
Regev-Rudzki, N. et al. Cell–cell communication between malaria-infected red blood cells via exosome-like vesicles. Cell 153, 1120–1133 (2013).
Mantel, P.-Y. et al. Malaria infected erythrocyte-derived microvesicles mediate cellular communication within the parasite population and with the host immune system. Cell Host Microbe 13, 521–534 (2013). Together with reference 129, this report presents the finding that RBCs infected with P. falciparum use microvesicles and exosomes to stimulate the production of transmission stages, and that these vesicles have immunomodulatory properties.
Martin-Jaular, L., Nakayasu, E. S., Ferrer, M., Almeida, I. C. & del Portillo, H. A. Exosomes from Plasmodium yoelii-infected reticulocytes protect mice from lethal infections. PLoS ONE 6, e26588 (2011).
Rongvaux, A. et al. Human hemato-lymphoid system mice: current use and future potential for medicine. Annu. Rev. Immunol. 31, 635–674 (2013).
Vaughan, A. M., Kappe, S. H. I., Ploss, A. & Mikolajczak, S. A. Development of humanized mouse models to study human malaria parasite infection. Future Microbiol. 7, 657–665 (2012).
Soulard, V. et al. Plasmodium falciparum full life cycle and Plasmodium ovale liver stages in humanized mice. Nat. Commun. 6, 7690 (2015).
Mikolajczak, S. A. et al. Plasmodium vivax liver stage development and hypnozoite persistence in human liver-chimeric mice. Cell Host Microbe 17, 526–535 (2015).
Mota, M. M. et al. Migration of Plasmodium sporozoites through cells before infection. Science. 291, 141–144 (2001). This study demostrates that sporozoites traverse several cells prior to switching from a traversal to an invasion mode in a final hepatocyte, in which they will fully develop.
Nacer, A. et al. Experimental cerebral malaria pathogenesis — hemodynamics at the blood brain barrier. PLoS Pathog. 10, e1004528 (2014). This exhaustive investigation uses IVM to elucidate the role of several leukocytes in the brain, finding that during cerebral malaria, a severe restriction in venous blood flow efflux from the brain results in oedema and, ultimately, cranial hypertension.
Kudryashev, M. et al. Positioning of large organelles by a membrane-associated cytoskeleton in Plasmodium sporozoites. Cell. Microbiol. 12, 362–371 (2010).
McMillan, P. J. et al. Spatial and temporal mapping of the PfEMP1 export pathway in Plasmodium falciparum. Cell. Microbiol. 15, 1401–1418 (2013).
Eaton, P., Zuzarte-Luis, V., Mota, M. M., Santos, N. C. & Prudêncio, M. Infection by Plasmodium changes shape and stiffness of hepatic cells. Nanomedicine 8, 17–19 (2012).
Luc´ic´, V., Rigort, A. & Baumeister, W. Cryo-electron tomography: the challenge of doing structural biology in situ. J. Cell Biol. 202, 407–419 (2013).
Oikonomou, C. M. & Jensen, G. J. A new view into prokaryotic cell biology from electron cryotomography. Nat. Rev. Microbiol. 14, 205–220 (2016).
Hanssen, E. et al. Electron tomography of Plasmodium falciparum merozoites reveals core cellular events that underpin erythrocyte invasion. Cell. Microbiol. 15, 1457–1472 (2013).
Nans, A., Mohandas, N. & Stokes, D. L. Native ultrastructure of the red cell cytoskeleton by cryo-electron tomography. Biophys. J. 101, 2341–2350 (2011).
Carzaniga, R., Domart, M.-C., Collinson, L. M. & Duke, E. Cryo-soft X-ray tomography: a journey into the world of the native-state cell. Protoplasma 251, 449–458 (2014).
Shroff, H., Galbraith, C. G., Galbraith, J. A. & Betzig, E. Live-cell photoactivated localization microscopy of nanoscale adhesion dynamics. Nat. Methods 5, 417–423 (2008).
Hell, S. W. Toward fluorescence nanoscopy. Nat. Biotechnol. 21, 1347–1355 (2003).
Folling, J. et al. Fluorescence nanoscopy by ground-state depletion and single-molecule return. Nat. Methods 5, 943–945 (2008).
Absalon, S., Robbins, J. A. & Dvorin, J. D. An essential malaria protein defines the architecture of blood-stage and transmission-stage parasites. Nat. Commun. 7, 11449 (2016).
Nakano, A. Spinning-disk confocal microscopy; a cutting-edge tool for imaging of membrane traffic. Cell Struct. Funct. 27, 349–355 (2002).
Svoboda, K. & Yasuda, R. Principles of two-photon excitation microscopy and its applications to neuroscience. Neuron 50, 823–839 (2006).
Bush, P. G., Wokosin, D. L. & Hall, A. C. Two-versus one photon excitation laser scanning microscopy: critical importance of excitation wavelength. Front. Biosci. 12, 2646–2657 (2007).
Chen, X., Nadiarynkh, O., Plotnikov, S. & Campagnola, P. J. Second harmonic generation microscopy for quantitative analysis of collagen fibrillar structure. Nat. Protoc. 7, 654–669 (2012).
Oron, D. et al. Depth-resolved structural imaging by third-harmonic generation microscopy. J. Struct. Biol. 147, 3–11 (2004).
Paddock, S. W. Principles and practices of laser scanning confocal microscopy. Mol. Biotechnol. 16, 127–149 (2000).
Kehrer, J. et al. R., A putative small solute transporter is responsible for the secretion of G377 and TRAP-containing secretory vesicles during Plasmodium gamete egress and sporozoite motility. PLoS Pathog. 12, e1005734 (2016).
Matz, J. M. et al. The Plasmodium berghei translocon of exported proteins reveals spatiotemporal dynamics of tubular extensions. Sci. Rep. 5, 12532 (2015).
Neuman, K. C. & Nagy, A. Single-molecule force spectroscopy: optical tweezers, magnetic tweezers and atomic force microscopy. Nat. Methods 5, 491–505 (2008).
Masedunskas, A. et al. Intravital microscopy: a practical guide on imaging intracellular structures in live animals. Bioarchitecture 2, 143–157 (2012).
Pittet, M. J. & Weissleder, R. Intravital imaging. Cell 147, 983–991 (2011).
de Moraes, L. V., Tadokoro, C. E., Gomez-Conde, I., Olivieri, D. N. & Penha-Gonςalves, C. Intravital placenta imaging reveals microcirculatory dynamics impact on sequestration and phagocytosis of Plasmodium-infected erythrocytes. PLoS Pathog. 9, e1003154 (2013).
Radtke, A. J. et al. Lymph-node resident CD8α+ dendritic cells capture antigens from migratory malaria sporozoites and induce CD8+ T cell responses. PLoS Pathog. 11, e1004637 (2015).
Lawton, J. C., Benson, R. A., Garside, P. & Brewer, J. M. Using lymph node transplantation as an approach to image cellular interactions between the skin and draining lymph nodes during parasitic infections. Parasitol. Int. 63, 165–170 (2014).
Ferrer, M., Martin-Jaular, L., Calvo, M. & del Portillo, H. A. Intravital microscopy of the spleen: quantitative analysis of parasite mobility and blood flow. J. Vis. Exp. http://dx.doi.org/10.3791/3609 (2012).
De Niz, M. et al. The machinery underlying malaria parasite virulence is conserved between rodent and human malaria parasites. Nat. Commun. 7, 11659 (2016).
Acknowledgements
The authors are grateful to J. Brewer, U. Frevert, M. Marti, C. Agop-Nersesian, R. Douglas, C. Grüring and B. Zuber for helpful comments and suggestions, and N. Brancucci for help with figure 4d. They also thank the Microscope Imaging Center (MIC) at the University of Bern, Switzerland, for outstanding technical support. M.D.N., H.A.P. and V.T.H. acknowledge funding from the European Union's Seventh Framework Program (grant 242095: EVIMalaR). T.S. acknowledges support from the research training group GRK1459 and the German Research Foundation (DFG) (grant SP1209/1). F.F. acknowledges support from the CellNetwork research cluster of Heidelberg University, Germany. Work in the F.F. laboratory is currently funded by grants from the DFG (SFB1129, FR 2140/6-1), the Human Frontier Science Program and the European Research Council. V.T.H. acknowledges support from the Swiss National Science Foundation (SNSF) (grant 310030–159519) and from SystemsX (grant 51RTPO_151032).
Author information
Authors and Affiliations
Corresponding authors
Ethics declarations
Competing interests
The authors declare no competing financial interests.
Supplementary information
Supplementary information S1 (movie)
Fluorescent sporozoites ejected from an immobilised Anopheles stephensi mosquito. Movie plays 20 times real time. Video was recorded at the Biology of Parasitism course in Woods Hole; courtesy of C. Nosala, University of California, Davis, USA, and F. Frischknecht, Universitätsklinikum Heidelberg, Germany. (MOV 89 kb)
Supplementary information S2 (movie)
Long term live imaging of liver stage parasites: Full development of mCherry-expressing parasite from invaded sporozoite to merozoite development. Host cell is expressing GFP-LC3. Video courtesy of J. Teutsch and V. Heussler, University of Bern, Switzerland. (AVI 2089 kb)
Supplementary information S3 (movie)
Live cell imaging: mCherry expressing sporozoite transmigrating and invading a GFP- expressing hepatocyte. Video courtesy of K. Rankin and V. Heussler, Bernhard Nocht Institute for Tropical Medicine, Hamburg, Germany. (MOV 1818 kb)
Supplementary information S4 (movie)
Fast-iterative imaging of 3D reconstructed PVM from PbEXP1-mCherry liver schizont (at 33hpi) recorded with 0.4 μm z-increments and 15 s intervals. It allows visualization of the complex architecture of the PVM and the dynamics of the TVN. Scale bar represents 10 μm. Video courtesy of C. Nersesian and V. Heussler, University of Bern, Switzerland. (AVI 582 kb)
Supplementary information S5 (movie)
Host actin reorganization event coinciding with P. berghei deformation and disappearance (red: mCherry:β-actin; green: GFP-Pb), scale bar represents 10 μm. Video reproduced from Gomes-Santos, C. S. S. et al. Highly dynamic host actin reorganization around developing Plasmodium inside hepatocytes. PLoS ONE 7, e29408 (2012). (MOV 925 kb)
Supplementary information S6 (movie)
Intravital imaging of parasite egress from the liver of an infected mouse. GFP-expressing sporozoites were used to infect a mouse and imaging of the exposed liver started at 44 hpi. Red fluorescent BSA was used to stain the blood vessels. Video modified from Sturm, A. et al. Manipulation of host hepatocytes by the malaria parasite for delivery into liver sinusoids. Science 313, 1287–1290 (2006). Reprinted with permission from AAAS. Sturm, A. et al. Manipulation of host hepatocytes by the malaria parasite for delivery into liver sinusoids. Science. 313, 1287–1290 (2006). (MOV 4451 kb)
Supplementary information S7 (movie)
Long term live imaging of P. falciparum blood stage parasite: The last part of schizont development followed by re-invasion by a merozoite and development of a ring stage parasite is shown. The time-lapse movie covers 620 minutes (125 time points, at 5 minute time intervals) and shows a single z-section of the z-stack collected for each time point. Video from Nature Publishing Group. Gruring, C. et al. Development and host cell modifications of Plasmodium falciparum blood stages in four dimensions. Nat. Commun. 2, 165 (2011). (MOV 3722 kb)
Supplementary information S8 (movie)
Rotation of a 3D reconstruction of an infected RBC, showing the TVN. Bodipy-TR-C5-ceramide (red) labels the host and parasite membranes and highlights the cavity. DAPI (blue) shows the parasite nucleus, while GFP (green) shows the Maurer's clefts. Video from Nature Publishing Group. Gruring, C. et al. Development and host cell modifications of Plasmodium falciparum blood stages in four dimensions. Nat. Commun. 2, 165 (2011). (MOV 564 kb)
Glossary
- Sporozoite
-
A motile, crescent-shaped stage of Plasmodium spp. parasites; sporozoites are injected into a mammalian host by a mosquito vector.
- Gametocytes
-
Sexual stages of Plasmodium spp. parasites. Gametocytes are either male or female gamete precursors and are solely responsible for transmission of the parasite from the vertebrate host to the mosquito.
- Oocysts
-
Cysts that develop from parasite ookinetes on the outside of the mosquito midgut, under the basal lamina, and in which asexual replication produces hundreds of sporozoites.
- Secretory vesicles
-
Membrane-bound vesicles that are derived from intracellular organelles and contain material for transport beyond the plasma membrane.
- Subpellicular network
-
(SPN). A skeletal component of organisms such as Plasmodium spp., consisting of a network of intermediate filaments on the cytoplasmic side of the inner membrane complex (IMC).
- Pore-forming proteins
-
Secreted, monomeric, water-soluble proteins that, in proximity to membranes, oligomerize into ring-like structures to enable membrane insertion and pore formation.
- Actin
-
A highly abundant structural protein that exists in a monomeric globular form (G-actin) and can polymerize into microfilaments (F-actin) to form the actin cytoskeleton, which supports cellular shape and cell migration, and provides tracks for the transport of vesicles and organelles within the cell.
- Basal lamina
-
A layer of extracellular matrix that is secreted by epithelial cells and on which the epithelium lies.
- Merozoites
-
Daughter parasites that originate from the asexual replication of certain apicomplexan parasites in infected red blood cells or hepatocytes. Merozoites can invade and infect red blood cells.
- Merosomes
-
Hepatocyte-derived membrane vesicles that contain a few to thousands of infectious merozoites that are extruded into the blood circulation.
- Sinusoids
-
Low-pressure, discontinuous blood vessels with a high rate of metabolite and nutrient exchange. Permeability in the sinusoids is enhanced by intercellular clefts and fewer tight junctions in the underlying endothelium.
- Circumsporozoite protein
-
(CSP). The most abundant surface protein of Plasmodium spp. sporozoites. CSP is involved in initial hepatocyte binding and invasion.
- Highly sulfated proteoglycans
-
(HSPGs). A family of glycoproteins that are highly sulfated by covalently attached heparan sulfate chains. These glycoproteins are presented on the cell surface for ligand interaction and are found in all vertebrate tissues, but are highly enriched in the liver.
- Cell traversal
-
Behaviour that is displayed by Plasmodium spp. sporozoites and ookinetes, involving the breaching of the plasma membrane of a host cell, gliding through the host cytosol and exiting the host cell.
- Kupffer cells
-
Phagocytic cells, also known as resident stellate macrophages, that line the sinusoids of the liver.
- Inner membrane complex
-
(IMC). An organelle of all alveolate organisms that consists of flattened vesicles which underlie the plasma membrane and are interconnected with the cytoskeleton.
- Schizogony
-
A mode of asexual replication in which several rounds of mitosis generate a multinucleated cell. In Plasmodium spp., schizogony is followed by cytokinesis to form individual infectious merozoites.
- Selective autophagy
-
Selective targeting of damaged cell organelles, large protein aggregates or intracellular pathogens for degradation in autophagosomes.
- Canonical autophagy
-
An intracellular self-degradative process that delivers cytoplasmic constituents to the lysosome and is important for balancing sources of energy in response to nutrient stress or at key stages of cell development.
- Gelsolin
-
An actin-binding protein that regulates actin filament assembly and disassembly.
- UBC–eGFP mouse
-
A transgenic mouse that expresses enhanced GFP (eGFP) under the control of the ubiquitin C (UBC) promoter in all tissues.
- Knobs
-
Protrusions, or knob-like raised platforms, on the surface of Plasmodium falciparum-infected red blood cells. These knobs are formed by the self-assembly of the parasite protein knob-associated histidine-rich protein (KAHRP) and enable the presentation of erythrocyte membrane protein 1 (PfEMP1).
- Rhoptries
-
Specialized secretory organelles that are positioned at the apical end of certain stages of apicomplexan parasites, including Plasmodium spp. sporozoites and merozoites. They have a function in host cell invasion and the formation of the parasitophorous vacuole membrane.
- Dense granules
-
Specialized secretory organelles that are positioned at the apical part of certain stages of apicomplexan parasites, including Plasmodium spp. sporozoites and merozoites. They are involved in host cell modification during invasion.
- Micronemes
-
Specialized secretory organelles that are positioned at the apical end of apicomplexan parasites, including all motile Plasmodium spp, stages. They function in host cell adhesion and motility.
- Myosin
-
A large family of ATP-dependent motor proteins that bind to and translocate cargo along actin filaments.
- Echinocytosis
-
The formation of an abnormal cell membrane with multiple small, evenly spaced projections. This phenomenon is unique to red blood cells and is often induced by Plasmodium spp. invasion.
- Mesoscopic imaging
-
An imaging modality with penetration depths of up to 10 mm and resolutions of below 100 μm, depending on the tissue type and wavelength of operation. Examples include fluorescence tomography and optoacoustic imaging.
- Microvesicles and exosomes
-
Forms of extracellular vesicle that represent an important mode of intercellular communication and are capable of transferring cytosolic proteins, lipids and RNAs between cells. Although a precise definition for each type of vesicle is lacking, exosomes are typically characterized as < 100 nm, whereas microvesicles are defined as 100–1,000 nm.
- Hypnozoites
-
Liver-stage parasites (Plasmodium vivax or Plasmodium ovale) that enter a latent, non-replicative state shortly after hepatocyte invasion. These dormant hypnozoites can be reactivated to complete liver-stage development thus causing a blood-stage infection in the range of weeks to years after an initial infection.
Rights and permissions
About this article
Cite this article
De Niz, M., Burda, PC., Kaiser, G. et al. Progress in imaging methods: insights gained into Plasmodium biology. Nat Rev Microbiol 15, 37–54 (2017). https://doi.org/10.1038/nrmicro.2016.158
Published:
Issue date:
DOI: https://doi.org/10.1038/nrmicro.2016.158
This article is cited by
-
Deep learning image analysis for continuous single-cell imaging of dynamic processes in Plasmodium falciparum-infected erythrocytes
Communications Biology (2025)
-
Molecular architecture of glideosome and nuclear F-actin in Plasmodium falciparum
EMBO Reports (2025)
-
EXIT-Strategien intrazellulärer Parasiten im Visier hochauflösender Bildgebung
BIOspektrum (2025)
-
Nanoscale insights into hematology: super-resolved imaging on blood cell structure, function, and pathology
Journal of Nanobiotechnology (2024)
-
Let it glow: genetically encoded fluorescent reporters in Plasmodium
Malaria Journal (2024)